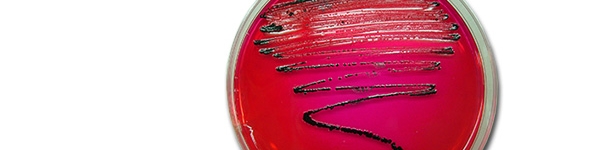
Aislamiento de Salmonella en XLD. En este medio las colonias de salmonella crecen de color negro debido a la producci&oacute;n de &aacute;cido sulfhidrico.

El control de Salmonella en porcino en la actualidad
Los planes de control, que debían haber comenzado en 2012, siguen sin estar implantados en la mayoría de los países europeos a día de hoy.
Noticias, eventos y reportajes de actualidad del sector porcino
Los eventos del sector porcino que se organizan en todo el mundo
Forum de discusión sobre temas relacionados con el sector porcino
Un resumen semanal de las novedades de 3tres3.com
Boletín de noticias sobre el mundo del porcino
La salud del porcino: noticias y artículos sobre PRRS, PCV2, bioseguridad, etc., guía de enfermedades del cerdo, atlas de patología, casos clínicos...
Biocheck.UGent es un sistema de puntuación científico independiente, basado en riesgos, para evaluar la calidad de su bioseguridad en la granja.
Cómo realizar una necropsia en un cerdo, paso a paso, de una forma muy visual y práctica.
Toda la información sobre PPA: cómo reconocer la enfermedad, cómo se transmiste, imágenes de lesiones, últimas noticias, guías,...
Toda la información sobre Fiebre Aftosa en porcino: cómo reconocer la enfermedad, cómo se transmiste, imágenes de lesiones, últimas noticias, guías,...
Descripción de las enfermedades y afecciones más importantes en porcino
Lesiones y signos de las principales enfermedades porcinas
Herramienta para diagnosticar enfermedades del porcino
Un diccionario sobre terminología específica del sector porcino
Calcula la cantidad de medicamento a incorporar en el agua cuando usamos un dosificador de flujo
Un resumen semanal de las novedades de 3tres3.com
Precios del cerdo por países. Producción y comercio de carne de cerdo. Noticias del mercado del porcino y las materias primas
Últimas cotizaciones de los mercados mundiales más importantes del porcino. Históricos de precios en diversas monedas y en formato gráfico.
Últimas cotizaciones de las principales materias primas para piensos. Gráficas históricas junto con el precio del cerdo y estimación del precio del pienso.
Últimas cotizaciones de los principales cortes de carne de cerdo. Históricos de precios en diversas monedas y en formato gráfico.
Calcula tu coste de producción, compáralo con la referencia y valora como afecta cada parámetro al coste de producción total y al margen
Datos de censos, producción y comercio de carne.
Datos de producción y comercio mundial de las principales materias primas
Cotizaciones de porcino ibérico en las lonjas de Extremadura, Salamanca y Araporc.
Un resumen semanal de las novedades de 3tres3.com
Información semanal del precio del cerdo y materias primas además de un índice de materias primas.
Artículos sobre nutrición y alimentación de cerdos, características de las materias primas y aditivos para porcino y precios de las materias primas
Últimas cotizaciones de las principales materias primas para piensos. Gráficas históricas junto con el precio del cerdo y estimación del precio del pienso.
Datos de producción y comercio mundial de las principales materias primas
Fichas técnicas de las principales materias primas y aditivos. Incluyen información de valores nutricionales, producción y comercio, estudios recientes, ...
Un diccionario sobre terminología específica del sector porcino
Utiliza esta herramienta para diagnosticar problemas con el índice de conversión. Haz click en el diagrama de flujo o en los botones dentro del texto para navegar por las distintas partes de la herramienta.
Un boletín quincenal con las últimas novedades sobre la nutrición porcina
Artículos sobre genética y reproducción en el porcino: selección genética, genómica, inseminación artificial, uso de hormonas...
Compara los datos productivos, calcula el número de plazas para cerdas, transición y cebo y visualiza tus tareas sobre el calendario según cada tipo de MEB.
Calcula las entradas de cerdas necesarias en una granja en activo, una granja que inicia la actividad o una granja que amplia
Herramienta para comparar los datos reproductivos de tu granja con la base de datos BDporc y ver la evolución de los parámetros reproductivos de BDporc
Un diccionario sobre terminología específica del sector porcino
Utiliza esta herramienta para investigar porqué tu tasa de partos es inferior a la ideal. Clica en el diagrama de flujo o en los botones dentro del texto para navegar por las distintas partes de la herramienta.
Un resumen semanal de las novedades de 3tres3.com
Manejo y gestión de las granjas de cerdos y organización del trabajo en cada una de las fases de producción: manejo en gestación, cebo, manejo en bandas...
Compara los datos productivos, calcula el número de plazas para cerdas, transición y cebo y visualiza tus tareas sobre el calendario según cada tipo de MEB.
Calcula tu coste de producción, compáralo con la referencia y valora como afecta cada parámetro al coste de producción total y al margen
Calcula las entradas de cerdas necesarias en una granja en activo, una granja que inicia la actividad o una granja que amplia
Herramienta para comparar los datos reproductivos de tu granja con la base de datos BDporc y ver la evolución de los parámetros reproductivos de BDporc
Aquí puedes comparar diversos objetos o juguetes usados como material de enriquecimiento con el objetivo de prevenir las mordeduras de cola en cerdos.
Un diccionario sobre terminología específica del sector porcino
Un resumen semanal de las novedades de 3tres3.com
Diseño de instalaciones y equipos para granjas de cerdos: diseño de naves, climatización, sistemas de alimentación, etc. Comparadores de equipamiento.
Biocheck.UGent es un sistema de puntuación científico independiente, basado en riesgos, para evaluar la calidad de su bioseguridad en la granja.
¿Qué tolva se adapta mejor a mis necesidades? Aquí puedes comparar las características de diversas tolvas comerciales.
¿Qué bebedero se adapta mejor a mis necesidades? Aquí puedes comparar las características de diversos bebederos comerciales.
Calculadora de la Huella Ambiental a lo largo de la cadena de valor del sector porcino
Un diccionario sobre terminología específica del sector porcino
Utiliza esta herramienta para investigar que estrategia de gestión de purines se adapta mejor a tu situación. Clica en el diagrama de flujo o en los botones dentro del texto para navegar por las distintas partes de la herramienta.
Un resumen semanal de las novedades de 3tres3.com
Información sobre el sector cárnico porcino: noticias, legislación, artículos sobre calidad, higiene, seguridad alimentaria, etc. y precios de la carne.
El manual agrupa un conjunto de herramientas que facilitan la gestión de la seguridad alimentaria para las empresas del sector cárnico porcino.
Últimas cotizaciones de los principales cortes de carne de cerdo. Históricos de precios en diversas monedas y en formato gráfico.
Datos de censos, producción y comercio de carne.
Las novedades sobre la carne de cerdo en 3tres3.com
Aquí encontrarás los autores especialistas en porcino que colaboran en 3tres3.com con información de su curriculum
Nacido en Castrocontrigo (León) el 27-mayo-1955, Pedro Rubio se graduó con Premio Extraordinario de Licenciatura en la Facultad de Veterinaria de León en 1981.
Desde septiembre de 1981 hasta enero de 1983 trabajó como veterinario en una explotación con 1.400 cerdas en ciclo cerrado y 800 vacas frisonas en producción.
Se incorporó en 1983 como Profesor Ayudante a la entonces Cátedra de Enfermedades Infecciosas de la Facultad de Veterinaria de León realizando su Tesis Doctoral sobre infecciones por coronavirus y por rotavirus del cerdo bajo la dirección del Profesor Pedro Cármenes. En 1988-1989 realizó una estancia postdoctoral en el Laboratorio de virología de la Facultad de Veterinaria de Gante bajo la dirección del Profesor Pensaert.
En 1989 obtuvo una plaza de Profesor Titular y tras el prematuro fallecimiento de Pedro Cármenes en 1996, dirige un grupo de investigación especializado en infecciones digestivas del cerdo.
En 1999 obtuvo la plaza de Catedrático de Enfermedades Infecciosas y Epidemiología del Departamento de Sanidad Animal de la Universidad de León. Es Director del Instituto de Desarrollo Ganadero y Sanidad Animal de la Universidad de León, miembro por curriculum del European College of Pig Health Management y miembro del grupo de trabajo sobre “Salmonelosis Porcina” de la Agencia Europea de Seguridad Alimentaria.
Ha dirigido 12 Tesis Doctorales en el marco de más de 20 proyectos de investigación de convocatorias públicas o financiados por empresas. Ha publicado sus trabajos de investigación en revistas científicas referenciadas en el JCR así como diversos artículos de divulgación en revistas nacionales y ha sido invitado a pronunciar numerosas conferencias en Congresos, Cursos y Jornadas Técnicas nacionales e internacionales.
Colabora como asesor con empresas de producción porcina, con industrias cárnicas y con compañías farmacéuticas nacionales e internacionales.
Curriculum actualizado: 18-jul-2011

Los planes de control, que debían haber comenzado en 2012, siguen sin estar implantados en la mayoría de los países europeos a día de hoy.

Es necesario entender qué está sucediendo y qué circunstancias se están dando para que bacterias que están también en la microbiota de los lechones sanos se multipliquen de tal forma que sean capaces de causar diarrea.

En este artículo se analizará cuáles son los puntos críticos de contaminación por salmonela en el matadero así como qué medidas se pueden tomar para su control.
El riesgo de contaminación por salmonelas aumenta a lo largo de la cadena alimentaria, alcanzando el máximo en el matadero, por tanto, en este punto es donde las actuaciones llevadas a cabo pueden ser más eficaces.

La EPP tiene una distribución mundial y ha sido descrita en todos los países con una producción porcina significativa. Actualmente es muy difícil encontrar granjas negativas, incluso entre las de más alto nivel sanitario de países con un elevado control.

Independientemente de estudios previos que pueden consultarse en la bibliografía, reflejaremos a continuación los datos más recientes obtenidos del estudio epidemiológico que se ha realizado desde...
Bienvenido a 3tres3
Conecta, comparte y relaciónate con la mayor comunidad de profesionales del sector porcino.
¡Ya somos 208612 Usuarios!
Regístrate¿Ya eres miembro?Los usuarios pueden iniciar sesión con Google para personalizar su experiencia, guardar preferencias o acceder a funcionalidades adicionales




